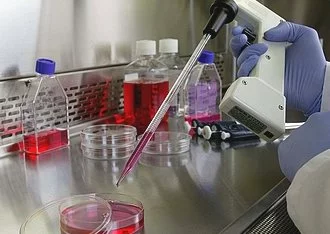

« Les jeunes pousses biotech vont consolider leur croissance »
« Les jeunes pousses biotech vont consolider leur croissance »
Grand entretien
Dimanche 25 janvier 2009 à 18h41
Selon François Lescure, président de MidiBiotech et vice-président du pôle de compétitivité Cancer-bio-santé, les jeunes pousses innovantes de l’agglomération dans le secteur de la (…)